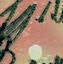
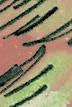

![]()

































By Christopher Adams

The scent of fresh pine and the spiritTree Sale Details






The sale was once located at West 15th and Industrial Road, but the construction of a new Walgreens forced the move to Guion’s Showcase.
“We’re very thankful for Guion’s allowing us to come down,” Fowler said. “When Walgreens wasbeen the biggest thing — moving us down to Sixth Street.”
While there may not be any standout stories from back year after year is the camaraderie — and the joy of seeing families make memories.
“It’s the camaraderie, raising money to fund and it’s a good time. It’s the right time of year — you with the new baby, that kind of thing. We’re really
As families haul their freshly chosen trees home,


Guion’s Showcase, West Sixth Avenue, Emporia Opens Black Friday (Nov. 28)
TREES: Canadian balsam fir, Fraser fir, Scotch pine, Eastern white pine
ALSO AVAILABLE: Wreaths and garland
Open daily until sold out (typically through mid-December)
FOR MORE INFORMATION: Contact any Flint Hills Optimist Club member


There’s no denying Christmas Eve is a little more special in homes where kids are excited about an overnight visit from Santa Claus. Indeed, kids’ joy and enthusiasm helps to make the holiday season such a special time of year. Since kids add so much to the holidays, it makes sense to prepare something special for youngsters. Of course, treats such as these “Christmas Tree Cake Pops” from Lines+Angles also may appeal to festive adults.
Makes 24 cake pops
1 box vanilla cake mix
3/4 cup canola oil
1/2 cup unsalted butter, softened
1 cup confectioners’ sugar
1 teaspoon vanilla extract
1 teaspoon milk
31/2 cups green candy melts
24 cake pop sticks
Icing dots
Icing stars
Prepare cake according to package instructions, adding 3/4 cup canola oil to the cake mix before baking.

Once cake is cool to the touch, transfer to a large mixing bowl and break up into crumbs. Allow to cool completely.
In a medium bowl, add the butter, sugar, vanilla, and
milk. Use an electric mixer and beat on medium speed for about 4 minutes until light and fluffy.
Add 3/4 of the frosting to the cake crumbs and mix until mixture can hold together well. Refrigerate for at least an hour.
Using your hands, shape the cake pop mixture into



24 conical shapes. Melt the green candy melts. Dip one end of each of the cake pop sticks into the melted chocolate before inserting into the bottom of the cake pops. Dip each cake pop into the melted chocolate, making sure to cover completely, allowing excess to drip back into bowl.
Use a toothpick to create the textured look of the tree and decorate with the icing dots and stars before standing upright to dry completely.


Various components come together to make the holiday season a festive time of year. There is a lot to get done in a short amount of time during the holiday season, and part of that includes shopping for all of the family members and friends on your shopping list. Shopping can be a complicated process that involves identifying which stores will be the best places to shop. Local retailers make the perfect place to shop for holiday items.
According to the American Express Business Economic Impact Study, more than two-thirds of every dollar spent with a local business stays in the community. Indeed, shopping local benefits consumer and community alike. The following are some of the many perks to shopping locally throughout the holiday season.
H Personalized attention:
Small businesses are known for their personalized customer service and owners and sta are often lauded for taking the time to interact and learn about their customers, a dynamic that is impossible at larger retailers.
H Shorter lines: Local stores are bound to have smaller crowds and thus shorter lines. That translates to less stress and hassle when it comes to getting in and out with holiday gifts.
H Smaller carbon footprint: Pollution, tra c congestion, habitat loss, and resource depletion may not occur on the same levels when shopping locally compared to patronizing big box stores. That’s because local retailers tend to create or source their products locally, whereas many big box stores secure their goods overseas.

H Meet and interact with people: Shopping in-person at local stores, you’ll see faces from your community and become better known in the local area.
H Easier parking: This goes hand-in-hand with smaller crowds, as shopping locally does not typically require driving up and down endless aisles at malls or standalone retail stores in an e ort to nd a parking spot. Local retailers in town may have on-street parking or closed lots that are convenient to shoppers.
H Small batch shopping experience: Consumers can secure items in small businesses that are not carbon copies of those found across the country at major retail chains. When seeking a unique, thoughtful gift, shopping locally is the way to go.












The holiday season is often characterized as the most festive time of year, and for good reason. Social schedules tend to be especially busy come the holiday season, when friends gather for nights out on the town and families reunite in the homes of welcoming hosts.
Celebrations are certainly on the mind between late November and early January, and many people like to toast this festive time of year with a cocktail. Perhaps no cocktail is a bigger part of holiday celebrations than eggnog, which is quite popular come December but not typically consumed throughout the rest of the year. This season’s celebrations might not be the same without eggnog, and amateur mixologists can keep that in mind and whip up this recipe for “Eggnog Christmas Milk Cocktail With Cinnamon” courtesy of Lines+Angles.
Makes 2 servings
2 ounces dark rum
2 ounces brandy
1 cup eggnog
1/8 teaspoon nutmeg
1/8 teaspoon cinnamon
1/8 teaspoon ground star anise
1/2 teaspoon demerara sugar
2 sticks cinnamon, for garnish
2 pods star anise, for garnish Shortbread cookies, for garnish and to serve (optional)
1. Mix the rum, brandy and eggnog in a cocktail shaker with ice.
2. Add the nutmeg, cinnamon, ground star anise and sugar to a small plate. Wet the rim of a glass with rum. Roll the rim of the glass in the spices.
3. Strain the eggnog mixture between the two glasses. Garnish with cinnamon sticks, star anise pods and festive shortbread cookies if desired.

The holidays are synonymous with many things, including various foods and beverages. Foodies know the holiday season is a time when baked goods, and cookies in particular, take center stage. Celebrants can keep that in mind and prepare a batch of these “Iced Cinnamon Star Cookies” from Lines +Angles this holiday season.
Makes 24 Servings
For the cookies:
21/2 cups almond our 11/4 cups powdered sugar
2 teaspoons ground cinnamon
1/4 teaspoon salt
2 large egg whites
1 teaspoon vanilla extract
For the icing:
1 cup powdered sugar
3 tablespoons milk, more if needed 1/2 teaspoon vanilla extract
For the cookies:
1. In a large bowl, whisk together almond flour, powdered sugar, cinnamon, and salt. Add the egg whites and vanilla and mix until a soft dough forms.
2. Wrap dough in plastic wrap and refrigerate for 30 minutes.
3. Preheat oven to 300 F. Line a cookie sheet with parchment paper.
4. On a surface dusted with powdered sugar, roll the dough to 1/3inch thickness. Cut out stars using a 3-inch star cookie cutter and transfer to the prepared cookie sheet.
5. Bake for 12 to 15 minutes until edges are lightly golden. Let cool on

baking sheets for 5 minutes, then transfer to wire racks.
For the icing:
1. Using a fork, combine the powdered sugar, milk, and vanilla. Use a whisk to continue to stir the icing, adding more milk, in teaspoon increments if needed, to reach desired consistency.
2. Once cookies are completely cooled, spoon the icing on top of each star and spread with the back of the spoon or a toothpick. You also can use a squeeze bottle or piping bag. Enjoy cookies immediately or let icing set at room temperature 6 to 8 hours.




















by Amanda Davis


For the past 90 years, Emporians have come together on the eve of the Christmas season to perform, sing, and usher in the holidays.
Nearly every student who grew up in Emporia remembers at least some involvement in the play. The Seasonal Celebration, a collaboration across numerous Emporia Public Schools, showcases hundreds of students musical talent, from dancing to vocal performance, to instrumental pieces.


The inaugural Seasonal Celebration lit up the stage in 1935, during the height of the Great Depression. At the time, it was simply known as “The Christmas Program”
Harry Hart, a Fine Arts Educator with the school district, kept the momentum alive for the program for years. Hart is responsible for some of the program’s longest held with red carpet.

part of the seasonal celebration,” Sarah Bays, EHS Director of Choirs, said. “We had a massive choir of typically around 300 children’s voices singing.”
recollects came in 1975. Don Grant, longtime EHS Choir




Director, invited Mic McGuire, an Emporia High School alum and world-touring opera singer, back to celebrate the milestone. Vinyl recordings were made of the performance, of which Bays holds around 50. To celebrate the program’s 90th year, Bays plans to distribute the recordings to those who may be interested.
In the early 1990s, The Christmas Program donned its current title of Seasonal Celebration. The USD 253 School Board made the switch to include more Christmas traditions that might not have previously been performed in the program’s previous iteration.
For the 75th celebration in 2010, Bays sent a performance invitation to Kelley Hunt, a nationally recognized blues musician and EHS graduate.
“In keeping with the tradition that had been established on the 50th,. I shot for the moon and got really lucky that blues musician Kelley Hunt answered my call and agreed to come and be our guest performer for the 75th,” Bays said. “It was really special.”
Bays plans to keep the guest performance tradition alive for the 90th anniversary. This time, the guest list features at least 90 people - alumni from EHS’s choir program.
“I’ve been wanting to put together an alumni choir, so rather than just getting in touch with people that made a career out of music, I wanted to involve people that just still love to sing, because singing is a truly lifelong activity,” Bays said.
Any EHS alumni who sang in the school choir are invited to participate in this year’s Seasonal Celebration.

“I’ve been wanting to put together an alumni choir, so rather than just getting in touch with people that made a career out of music, I wanted to involve people that just still love to sing, because singing is a truly lifelong activity.”

Over 90 graduates from as early as the class of 1967, have already volunteered to sing. For many former students returning, the performance feels like coming home.
“A lot of former students say that Seasonal Celebration season,” Bays said. “A lot of them really try each year to come back to the performance, because it has truly become part of their celebration and it’s a big part of the culture of our town.”
The Seasonal Celebration will commence on Dec. 10, at 7:00 p.m., located in the Civic Auditorium. To inquire about receiving a vinyl recording of the 50th celebration, or to participate in the 90th celebration alumni choir, contact Bays at sarah.bays@usd253.net.

by Austin Hoagland
The holidays just got a little more festive in Emporia.
This year, the Emporia Chamber of Commerce, Visit Emporia and ESB Financial teamed up to announce the ESB Financial Holiday Plaza — a holiday attraction that will feature food trucks, festive decorations and a 60-by-40-foot synthetic ice rink.
Christian Keisler, interim president of the Emporia Chamber of Commerce, hopes the new plaza becomes a source of holiday joy for Emporians — all without breaking the bank.
“Emporia doesn’t have a lot in the wintertime to do for families,” Keisler said. “So we wanted to make something that was affordable but also a lot of fun and different.”
The concept for the rink came from a discussion between Keisler and other community leaders attempting to brainstorm holiday-themed activities. The discussion turned to what worked
in other communities, particularly the success of the ice rink at Crown Center in Kansas City.
This inspiration led to the idea that would become the ESB Financial Holiday Plaza, but the rink in Emporia will have one major difference from Crwon Center: it will not be made from actual ice, but from high-density synthetic polymers that interlock like puzzle pieces to create a solid skating surface.
This plastic substance is infused with a proprietary glide agent to mimic the real feel of skating on ice without creating issues caused by weather, maintenance, and expensive upkeep.
Using synthetic over real ice means not having to pay for refrigeration machines, electricity, water supply and the infrastructure required to maintain a real ice rink, costs that would make the rink unfeasible for a city like Emporia.

After Keisler and other community organization leaders decided to move forward with the idea for a synthetic ice rink, he needed to find a local business partner. The installation of the rink happened to perfectly coincide with the 125th anniversary of ESB Financial, who quickly became interested in the project following a conversation with Keisler.
“We immediately felt it was a perfect fit to help kick off ESB Financial’s 125th Anniversary,” said Kandace Wakeman, marketing officer at ESB Financial. “We knew right away that we wanted to be part of something that would bring joy, connection and tradition to downtown Emporia.”
What started as a simple ice rink turned into something much more. The idea quickly expanded into a full plaza, equipped with decorations, food and drinks, and ready to serve as a host for holiday events or parties.
While bringing some of those ideas to life may take years, the team behind the rink will have plenty of time to make them happen.
Keisler said that because the cost difference between renting the synthetic ice panels and purchasing them was minimal, the Chamber decided to buy them outright. He expects the panels to last 12 to 20 years, depending on how well they are maintained.
When the panels are not being used, the panels will be stored in a shed, ready to be pulled out again when the holiday season
starts again.
Keisler hopes to add more events and experiences to the plaza in future years, aiming to build on the holiday atmosphere and keep Emporians returning each season. Some ideas that have been floated include selling Christmas trees and more events with Christmas icons like reindeer and Santa himself.
The location for the rink is not set in stone, and Keisler says that it may change to best match the ideal atmosphere for Emporians.
Ideally, he hopes that Emporians could do all of their Christmas shopping and activities in one day. Buy a tree, skate on the rink, and shop for gifts at many of the local businesses lining the downtown streets.
“We’ve got so many mom-and-pops, we want to make sure that they’re supported,” Keisler said. “It’s very easy for families just to load up and go out of town to do these things. So if we can create that here, hopefully they stay here, and they can shop, enjoy the community and also not feel like they have to travel an hour to go ice skate.”
Keisler, a native Emporian, recalls having to travel all the way to Topeka and Wichita just to see a mall santa. Not being able to create holiday memories in his hometown provided motivation to ensure families in Emporia would not have to drive an hour or more to make Christmas feel special.
“I want them to have those memories here



“We knew right away that we wanted to be part of something that would bring joy, connection and tradition to downtown Emporia.”
— Candace Wakeman
and say, ‘Hey, I remember when I was a kid, I went down to the skating rink and we did this,’” said Keisler. “Let’s create memories and make sure that those are everlasting.”
One thing that continued to come up as a reason to bring this kind of project to Emporia, in Keisler’s mind, was the negativity that he saw when discussing the city. Between bouts of unemployment struggles, business closures, and much more, he feels that the conversation around Emporia has a distinct air of negativity that he hopes will subside with something that could bring the community together.
“I want this community to feel the joy again,” Keisler said. “Around the world, there’s so much negativity. You’re in a small community — let’s all enjoy it. Have fun with each other. And I’m hoping that kids, families, everybody will just get out there and just laugh and smile.”
The plaza will be open at 923 Commercial St. from Nov. 20 and run through the end of January.
Symbolism features prominently throughout the holiday season. When walking around in December, or even earlier, individuals can’t help but notice lighting displays, decked out Christmas trees in town centers and other symbols that are synonymous with the holiday season.
Gingerbread houses may or may not be on public display, but these impressive constructions are yet another notable sign that the holiday season has arrived. As families prepare to celebrate the holiday season, they can work together to create this impressive, and edible, “Gingerbread House” courtesy of Lines+Angles.
Makes 8 servings or 1 house
For the house:
31/4 cups all-purpose our, plus extra as needed
3 tablespoons cornstarch
1 tablespoon ground ginger
3/4 teaspoon ground cinnamon
3/4 teaspoon salt
1 cup unsalted butter, at room temperature
3/4 cup molasses, warmed
1 teaspoon vanilla extract
For the frosting:
2 cups confectioners’ sugar, plus extra as needed
11/2 tablespoons meringue powder
1 to 2 tablespoons warm water
To decorate:
Assorted colorful candies, sugared chocolate candies, round peppermint candies, candy canes, etc.
1. For the gingerbread: Combine the flour, cornstarch, spices, and salt in a large mixing bowl. Stir well and set aside.

2. Beat the softened butter with the molasses and vanilla in a separate mixing bowl until pale and creamy, about 2 to 3 minutes.
4. Turn out and knead briefly. Shape into a round, wrap in parchment paper, and chill for 2 hours.
5. After chilling, preheat the oven to 325 F. Grease and line 2 large
3. Beat in the flour mixture in 4 additions, mixing well between additions until you have a rough dough; add more flour as needed to form a stiff dough.
baking sheets with parchment paper.
6. Remove the dough from the refrigerator. Roll out to about 0.333”
7. Cut out two rectangles approximately 4.5” x 4” for the roof. Cut out 2 pointed rectangles approximately 5” at their tallest points and 3.5” wide at the base; these will be the front and back of the house as per the image. Make sure that one side has a round window cut out.
8. Using some of the remaining dough, cut out the 2 rectangles to be the sides of the house, approximately 3” x 4” in diameter. Use the remaining dough to cut out 4 even rectangles, approximately 2” x 1.5”, to shape the chimney.
9. Arrange the pieces across the baking sheets. Bake for about 25 minutes until browned and dry to the touch. Remove to cooling racks to cool.
10. For the frosting: Combine the

confectioners’ sugar, meringue powder and 2 tablespoons warm water in a large mixing bowl.
11. Beat with an electric mixer until the frosting is thick and glossy, about 4 to 5 minutes; beat in more confectioners’ sugar if too thin and more water if too thick.
with a thin, round nozzle. Chill for 15 minutes.
13. To decorate: Using the frosting as ‘glue,’ assemble the chimney using the 4 even rectangles of gingerbread. Let dry and set.
14. Start to assemble the rest of the house by glueing the pieces together as per the image, attaching the front and back of the house to the sides before attaching the roof in place. Let set dry and set at each building interval.
15. Once the sections are dry, pipe more frosting onto the edges of the roof and down their sides, shaped as icicles.

16. When the chimney is set, attach it to the top, cutting the pieces
outside with frosting.
17. To decorate: Attach the assorted candies to the house, decorating the roof with a tiled pattern using the frosting.
18. Let the house dry and set until ready to serve.
Preparation time: 2 hours
Cooling time: 2 hours, 15 minutes
Total time: 4 hours, 15 minutes
Difficulty:
Tips:
Some of the gingerbread pieces will bake quicker than others depending on their size; keep an eye on them and remove from the oven when ready.
Meringue powder is available online or from specialty cookware stores.


















